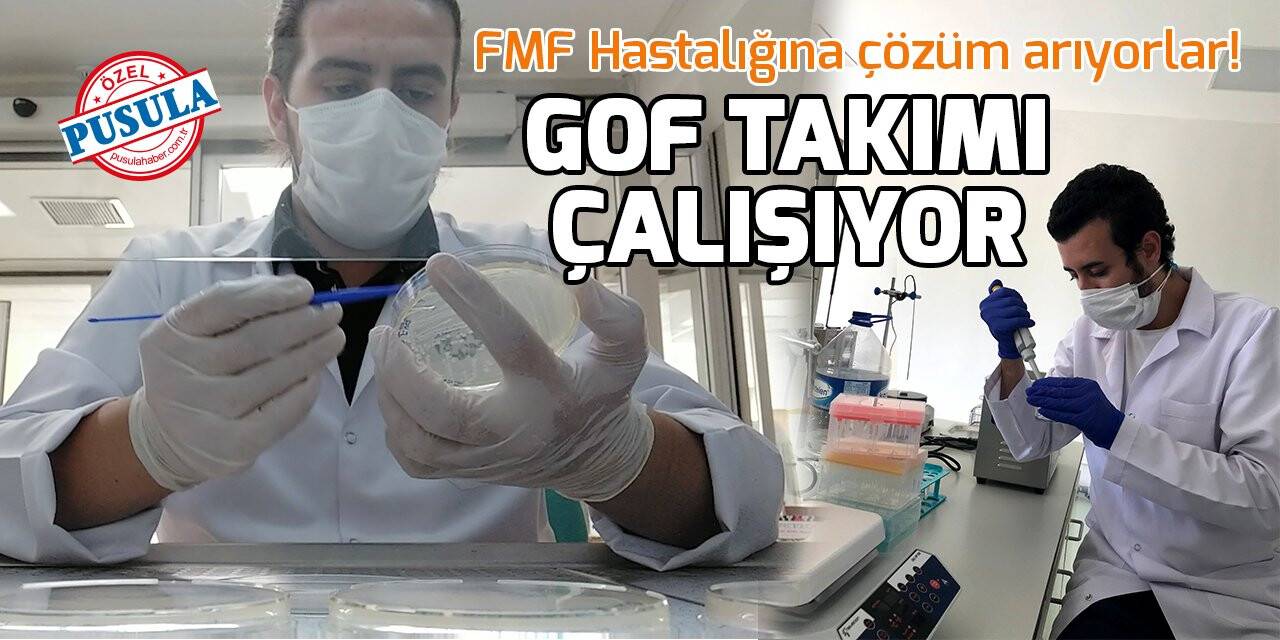
GOF Takımı FMF Hastalığına çözüm için çalışıyor

GOF Takımı FMF Hastalığına çözüm için çalışıyor
Necmettin Erbakan Üniversitesi (NEÜ) öğrencilerinden oluşan Genes Of The Future (GOF) Takımı, nadir hastalıklara genetik tedavi üretmek amacıyla İstanbul’da düzenlenen RaDiChal Yarışması’nda, Ailevi Akdeniz Ateşi (FMF) hastalığı alanında hazırladıkları genetik tedavi projesi ile birincilik elde etti. NEÜ Fen Bilimleri Enstitüsü Biyoteknoloji Ana Bilim Dalı Yüksek Lisans Öğrencisi Abdurrahim Toprak, Fen Fakültesi Biyoteknoloji Bölümü Mezunu Enes Buğra Yalçınkaya ve Biyoteknoloji Bölümü Öğrencisi Beyza Gül Ateşli’den oluşan GOF Takımı, lisans eğitiminde edindikleri bilgiler ile Ailevi Akdeniz Ateşi hastalığına genetik tedavi projesi yazarak yarışmada ‘En İyi FMF Proje Ödülü’ ve altın madalya ödülüne layık görüldü.

ATEŞLİ: YARIŞMAYA KATILDIKTAN SONRA FMF OLDUĞUMU ÖĞRENDİM
Türkiye’de her beş kişiden birinin taşıyıcı ya da FMF Hastası olduğunu söyleyen Biyoteknoloji Bölümü Öğrencisi Beyza Gül Ateşli, “Bizde bu hastalığı farkındalık oluşturmak adına seçtik. FMF Hastalığı Yahudi, Arap, Türk ve Ermeni kökenlilerde görülüyor. Yani Akdeniz Havzası’nda görüldüğü için Ailevi Akdeniz Ateşi ismi veriliyor. En yaygın belirtileri; karın ağrısı, yüksek ateş, eklem ve bilek ağrıları, kas ağrıları ve deri döküntüleridir. FMF nadir hastalıklardan olarak görülse de Türkiye’de artık çok fazla görülüyor. RaDiChal Yarışması’nda da, her yıl üç genetik hastalık seçiliyor. Ve bunun üzerine projeler yazılıyordu. Bizde FMF hastalığını seçmek istedik” dedi. Yarışmanın İstanbul’da Üsküdar Üniversitesi’nde düzenlendiğini belirten Ateşli, “Bu yarışmaya katıldıktan birkaç gün sonra çok enteresan bir şey oldu ve bana FMF Hastalığı teşhisi koyuldu. Hasta olduğumu öğrendikten sonra ben ve arkadaşlarım için aslında işler çok değişti. Hastalığı içselleştirip daha farklı bir ruh haline büründük. Aslında bunu ben bir motivasyon kaynağı olarak da gördüm” diye konuştu.

TOPRAK: HEDEFİMİZ GELECEK NESİLLERE AKTARILMASINI ÖNLEMEK
Projelerinin patentini almak istediklerini söyleyen NEÜ Fen Bilimleri Enstitüsü Biyoteknoloji Yüksek Lisans Öğrencisi Abdurrahim Toprak, “Biyoteknoloji konusunda çalışmalarımız kesintisiz devam edecek. Bu hastalık genetik bir hastalık olduğu için şu anda bir tedavisi yok. Sadece ilaç tedavisi oluyor. Onlarda ağrılı atakları azaltmak için. En kötü yanı genetik olduğu için nesilden nesile geçiyor. O yüzden biz projemizi hayata geçirmek için çok heyecanlıyız. Bizim projedeki hedefimiz gelecek nesillere aktarılmasını önlemek. İnşallah hayata geçirdiğimiz zaman FMF hastalığına umut olacağını düşünüyoruz. Fakat bu projenin laboratuvara inmesi için ve en kısa zamanda çalışmalarımıza başlamamız için sponsora ihtiyacımız var. Mesela bu sene 25 takım finale kaldı. Bu takımların hepsine sponsor bulunsa belki çok yeni tedaviler bulunacak. Mesela biz bu yarışmaya girerken de katılım ücretini ödeyemedik. Sonra ücretsiz çekiliş hakkı verildi takımlara. Çekilişe katıldık. Bize de katılma hakkı çıktı. Bu sayede birinci olduk. Yani maddi sorunlar aşıldığında bizim ve diğer takımların yapamayacağı şey yok diye düşünüyorum ” dedi.

YALÇINKAYA: FMF’DE YÜZDE 80 HASTALARA TEDAVİ OLACAK
Sosyal farkındalıklar konusunda ellerinden geleni her zaman yapmaya çalıştıklarından bahseden Fen Fakültesi Biyoteknoloji Bölümü Mezunu Enes Buğra Yalçınkaya, “Doktorlardan, hastalardan, hasta yakınlarından hastalığı dinledik. Araştırmalarımıza da bu süre zarfında devam ettik. Daha sonra FMF Hastalığının mutasyonlarının çoğunu kapsayan bir proje yazdık. Proje için aylarca uğraştık diyebilirim. Çabalarımız sonuç verdi ve birinci olduk. Bu projemiz hayata geçerse FMF’de yüzde 80 hastalara tedavi olacak ve gelecek nesillere de aktarılmayacak” dedi. 12 farklı şehirde afiş çalışması yaptıklarını, 8 farklı şehirde de el broşürü hazırladıklarını belirten Yalçınkaya, “Sosyal medya üzerinden de bu konu ile alakalı canlı yayın ve paylaşımlar yapıyoruz. Çünkü FMF ve diğer nadir hastalıklar insanlar tarafından yeterince bilinmiyor” diye konuştu. (Gülşen Çopur)














Türkçe karakter kullanılmayan yorumlar onaylanmamaktadır.